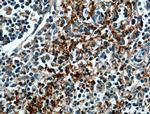
CD42b Antibody in Immunohistochemistry (Paraffin) (IHC (P))

Search
Proteintech
CD42b Polyclonal Antibody
{{$productOrderCtrl.translations['antibody.pdp.commerceCard.promotion.promotions']}}
{{$productOrderCtrl.translations['antibody.pdp.commerceCard.promotion.viewpromo']}}
{{$productOrderCtrl.translations['antibody.pdp.commerceCard.promotion.promocode']}}: {{promo.promoCode}} {{promo.promoTitle}} {{promo.promoDescription}}. {{$productOrderCtrl.translations['antibody.pdp.commerceCard.promotion.learnmore']}}
产品信息
12860-1-AP
种属反应
已发表种属
宿主/亚型
分类
类型
抗原
偶联物
形式
浓度
规格
纯化类型
保存液
内含物
保存条件
运输条件
产品详细信息
Immunogen sequence: ICEVSKVAS HLEVNCDKRN LTALPPDLPK DTTILHLSEN LLYTFSLATL MPYTRLTQLN LDRCELTKLQ VDGTLPVLGT LDLSHNQLQS LPLLGQTLPA LTVLDVSFNR LTSLPLGALR GLGELQELYL KGNELKTLPP GLLTPTPKLE KLSLANNNLT ELPAGLLNGL ENLDTLLLQE NSLYTIPKGF FGSHLLPFAF LHGNPWLCNC EILYFRRWLQ DNAENVYVWK QGVDVKAMTS NVASVQCDNS DKFPVYKYPG KGCPTLGDEG DTDLYDYYPE EDTEGDKVRA TRTVVKFPTK AHTTPWGLFY SWSTASLDSQ MPSSLHPTQE STK (19-350 aa encoded by BC027955)
靶标信息
CD42b is a platelet activation marker involved in the process of coagulation as an aggregating factor. It interacts with extracellular matrix as well as with adhesion molecules. CD42b expression and activation seems to be regulated by VEGF and PDGF. CD42b composes together with GPIb beta, GPIX and GPV the GPIb-IX-V receptor complex critical in the process of platelet-rich thrombus formation by tethering the platelet to a thrombogenic surface. CD42b binds to von Willebrand factor (VWF) exposed at a site of vascular injury, as well as to thrombin, coagulation factors XI and XII, high molecular wight kininogen, TSP-1, integrin Mac-1 and P-selectin. The extracellular domain of CD42b by its interactions also contributes to metastasis. Further, CD42b antigen is expressed on platelets and on megakaryocytes in bone marrow. Several polymorphisms and mutations have been described in the CD42b, some of which are the cause of Bernard-Soulier syndromes and platelet-type von Willebrand disease.
仅用于科研。不用于诊断过程。未经明确授权不得转售。
生物信息学
蛋白别名: Antigen CD42b-alpha; CD42a; CD42b; glycoprotein Ib (platelet), alpha polypeptide; glycoprotein Ib platelet alpha subunit; glycoprotein Ibalpha; GP-Ib alpha; GP-IX; GPIB; GPIb alpha; GPIX; MGC34595; mutant platelet membrane glycoprotein Ib-alpha; Platelet glycoprotein Ib alpha chain; platelet glycoprotein Ib alpha chain precursor; platelet glycoprotein Ib alpha polypeptide; Platelet GPIX; platelet membrane glycoprotein 1b-alpha subunit; platelet membrane glycoprotein Ib-alpha
基因别名: BDPLT1; BDPLT3; BSS; CD42B; CD42b-alpha; DBPLT3; GP1B; GP1BA; GPIBA; GPIbalpha; VWDP
UniProt ID: (Human) P07359, (Mouse) O35930
Entrez Gene ID: (Pig) 100515052, (Human) 2811, (Mouse) 14723